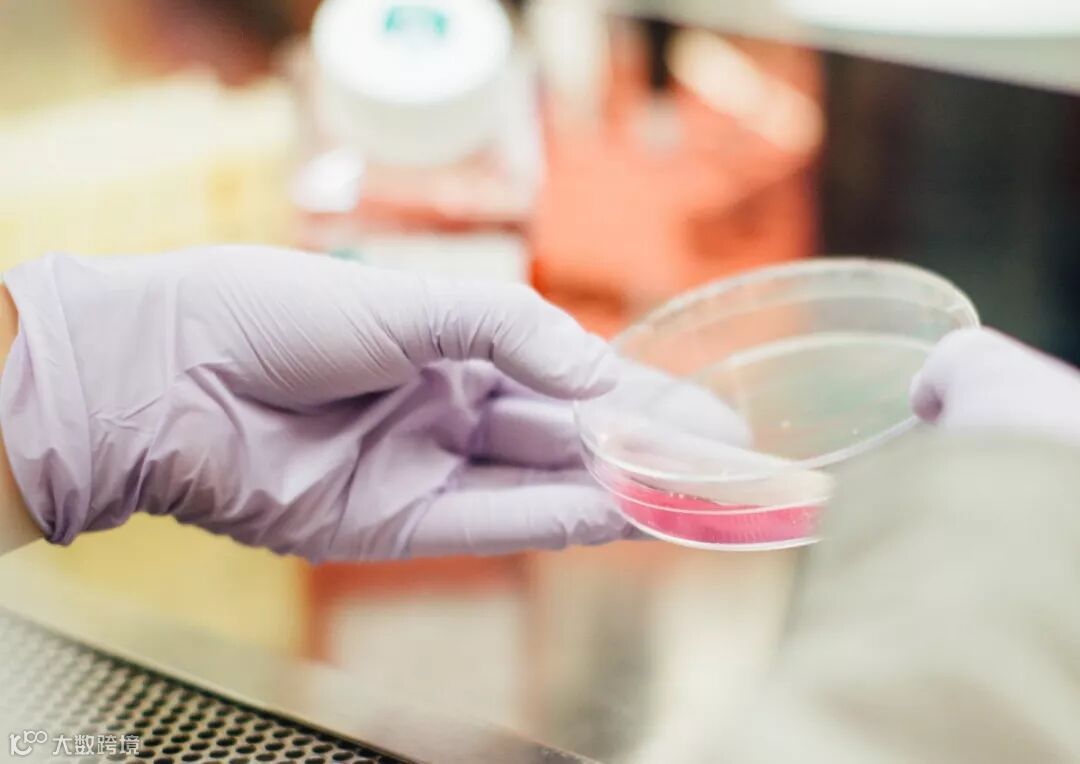

在纯水的储存过程中,二次污染导致的水质下降是很难避免的。那么,在储存过程中,导致水质劣化的因素有哪些呢?
1
由于纯水中溶解的离子浓度很低,外界环境中的污染物,如微生物、空气、有机物等很容易进入水中。非惰性的塑料和玻璃制造的储水器会溶出离子和有机物,电导率升高,水质劣化。因而推荐使用低溶出的聚乙烯或者含氟材质的储水器。
2
多数的储水器都有一个排气口用于取水期间空气的流通。通气口吸入外界空气的同时带入实验室空气中的CO²,细菌,颗粒和挥发性有机物,这些都将污染储存在水箱中的纯水。因而通气口应配置空气过滤器以阻止有机物,细菌和CO²进入水箱。
3
清洗过程中,平底水箱无法完全排空。这些未能排干的水容易形成湿润的环境,是细菌生长的一个根源,因此我们推荐使用锥形底的水箱以排干所有的水。
4
水箱应采用一次吹塑成型的方式制作,以防止多部件连接处及凹凸不平的表面为细菌提供生长繁殖的场所。
5
由于微生物的繁殖速度很快,即使少量的微生物残留,也能形成菌膜,引起水质劣化。所以安装一个能抑制细菌生长的消毒模块(UV灯)是很有必要的。
6
由于储存期间,纯水会与空气、管路、水箱等接触,随着储存时间的增长,水质会逐渐下降。为了保证取水水质的稳定,系统最好设置定时循环、强制循环功能,以解决纯水在储存期间的二次污染问题,以保证取水水质稳定。





